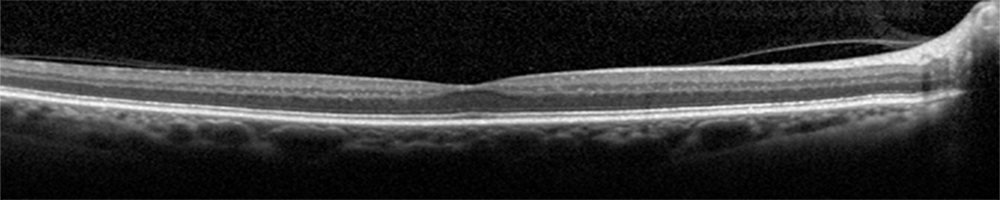
Challenge Banner

Retinal OCT Classification Challenge (ROCC)¶
Welcome to the Retinal OCT Classification Challenge (ROCC)!
ROCC is organized as a one day Challenge in conjunction with MVIP2017.

Retinal diseases, such as age-related macular degeneration (AMD) or diabetic retinopathy (DR), are the major cause of blindness in a large percentage of world population. These pathologies, currently affect over 8.7% of the world population and 159 million people worldwide, respectively. Retinal optical coherence tomography (OCT) imaging has become an indispensable diagnostic tool in Ophthalmology to early detect, treat and monitor these diseases. Automated retinal image analysis has the potential to improve the diagnostic process and make treatment monitoring more effective.
However, efficient leveraging key information for diagnosis is a complex task, since the retinal OCT images are corrupted by speckle noise, distorted with respect to the anatomy and the patient movement in the acquisition process, and of a wide range of varying image intensity. So, many traditional automated solutions and techniques do not suffice to accurately extract the required discriminative information.
A variety of successful algorithms for computer-aided analysis of retinal OCT images are presented in the literature, but the robust use in clinical practice is still a major challenge for ongoing research in OCT image analysis.
The goal of this challenge is to call different automated algorithms that are able to detect DR disease from normal retina on a common dataset of OCT volumes, acquired with Topcon SD-OCT devices. We made available a dataset of OCT volumes containing Normal and DR cases with accompanying reference annotations. We invite the medical imaging community to participate by developing and testing existing and novel automated retinal OCT image classification methods.